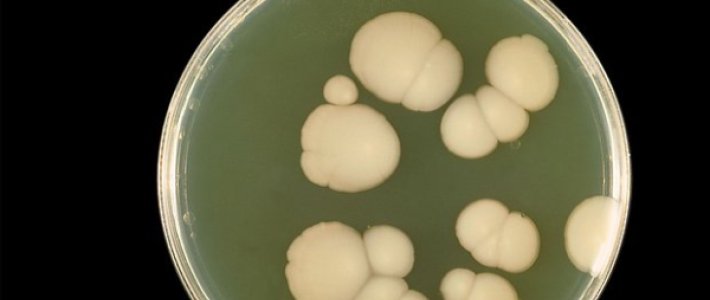

Грибки Фото
Половые Грибки Фото 114 фото
Валуев С Женой Фото В Полный Рост
Почему Фото Получаются Зеркальными
Маша Политова Дом 2 Фото
Лук Двухъярусный Фото Выращивание
Картинки Нарисованных Домов Карандашом
Картинки Поздравления С Новой Машиной
Картинки На Аватарку В Ватсап Грустные
Сорта Пеперомии Фото И Названиями Виды
Блокнотный Лист Картинки
Антуриум Кавалли Фото И Описание Сорта